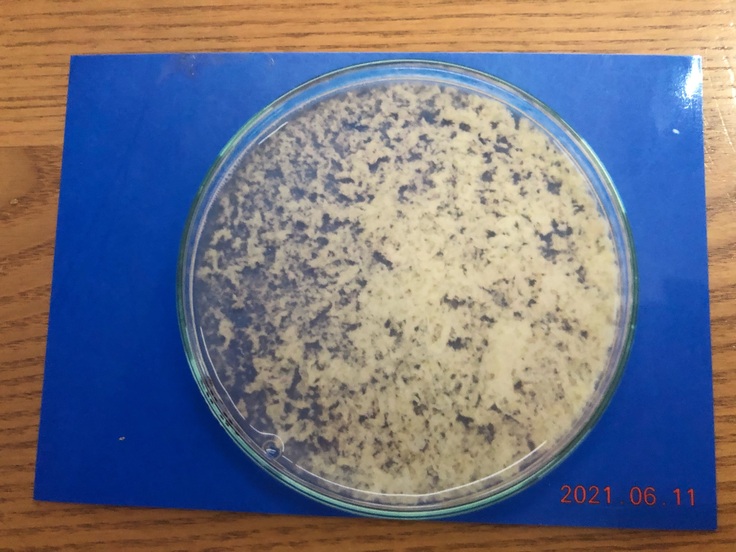

支援総額
目標金額 800,000円
- 支援者
- 154人
- 募集終了日
- 2021年8月9日

救う命を選ばない。どんな犬猫も保護し続け福岡の里親さんを増やしたい
#動物
- 現在
- 3,275,000円
- 支援者
- 314人
- 残り
- 5時間

“まあくんの家“応援隊募集‼︎行き先のない子達の医療と継続のために
#動物
- 総計
- 189人

JWCサポーター大募集中!傷付いた野生動物を救いたい
#子ども・教育
- 総計
- 253人

1頭1頭と向き合い続けるために。引退馬たちに安心安全な新厩舎建設へ
#観光
- 現在
- 74,041,000円
- 支援者
- 6,397人
- 残り
- 31日

【まあくんハウスマンスリーサポーター】保護した野犬・成犬に未来を
#フード
- 総計
- 71人

高齢の保護犬を救う!シニアドッグ・サポーター制度を応援してください
#動物
- 総計
- 18人

保護猫応援ファームのサポーター募集中!保護猫活動の継続支援を!
#子ども・教育
- 総計
- 13人
プロジェクト本文
終了報告を読む
▼半陰陽▼
ジジは男の子です。ですが今回体の中に女の子の臓器が見つかりました。
そこに大量の膿が溜まり、命に関わる重大な事態となりました。
▼費用
二次病院での手術、治療費:約80万円
1度目の手術+治療:約10〜15万円
手数料:9万6000
+今後こまめに腎臓の検査を3か月ごとに行い、治療を行って行きます。
高額医療費のご支援をどうかよろしくお願い致します。
▼自己紹介
皆様初めまして。このプロジェクトに目を止めていただき誠にありがとうございます。
私は1歳のキャバリア・ジジくんのママのおおしまです。
先住犬のキャバリアを15歳で亡くして数年が経ち、そんな時にペットショップで出会いました。家族になってからはとても懐っこく、犬も猫も人も大好きな愛嬌いっぱい天真爛漫の僕に毎日癒されています。
↑出会って初めての写真です。
ですが、迎え入れた2か月後に歩き方がおかしいことに気が付き獣医にいくと、本来ついていなければいけないところに靭帯がついていないことがわかりました。(現在は左足を主に使用して歩行しており、右足にはほとんど筋肉がありません)
ペットショップに連絡すると、生体交換といわれましたが、家族同然のジジを手放すという選択肢は1ミリもありませんでした。彼の宿命も受け入れ、犬生を全うさせてあげようと家族で誓いました。(生体交換を行わない場合、ペットショップからの治療費の援助は一切ありません。)
その後も、膀胱の形の奇形(本来は丸いがジジはひょうたん型)や、陰部の皮膚の奇形(入口が広がっており陰茎が戻らない)も見つかりました。それらには、今のところ命に関わる疾患とはなっていません。
今回、いつも落ち着きのないジジが元気がないため病院へ行くことになりました。
エコーの結果、オスにもかかわらず、腹部に子宮のようなものがあり、その異物が膨れ圧迫しているとの診断でした。
先生も「半陰陽(両方の性器をもつ)は獣医をしていても見れないことのほうが多い症例」とのことです。その臓器が圧迫している痛み、腸の圧迫があり便の形の異常まで見られていました。CRPも高値だったため、翌日(6/11)の夜間に子宮様のものの摘出手術の予約を入れその日は帰宅しました。
翌日朝(6/11)、餌を食べなくなりさらに元気がなくなってしまい、急遽朝来院し緊急手術となりました。
結果、摘出はできず。
・他臓器に癒着している。
・その中で大静脈に癒着が見られ、はがす際に大出血の可能性あり、飼い主の承諾なしで、命を危険にさらせない。
・小さな個人病院のため輸血等の対応が難しい。
とのことでした。
中には膿がたまっており、開放手術で膿のみ取り除いていただきました。
こちらが中にたまっていた膿の一部です。臓器の中にはこの何十倍も溜まっていたとのこと
↓沢山の菌が存在するそうです。
手術中の子宮様の内臓の写真もいただきましたが、苦手な方もおられると思いますので掲載は控えます。
↓現在は手術まで膿の発生を少しでも遅らせるように抗生物質の内服をしています。
手術翌日(6/12)ジジに会いに行きましたが、すでに再度膿がたまり始めているとのことです。
ご飯を食べなかったそうですが、私たちがあげると食べてくれました。
6/14にも病院へ行き、補液・抗生剤の注射・エコー検査をしました。
さらに膿がたまってきているようです。
個人の病院では手術は困難と判断され、第二次医療機関にかかることに…
2021/6/17に日本動物高度医療センター名古屋への受診が決定していましたが
尿が出なくなり、容体も悪くなり、立ち上がることができなくなりました。
そのため急遽6/16に受診し、輸血・点滴をし手術することになりました。
ジジを助けるためには、摘出手術しかありません。
高度医療センターで精密検査を行った結果、
子宮または尿管に膿がつまり膨れているかもしれないとのこと。
お腹を開けるまでは実際に何かはわからないといわれました。
右の腎臓は機能していなく摘出手術予定です。
左の腎臓も萎縮が始まっていますが、まだ大丈夫とのことです。
ですが尿管が圧迫されているため、もしかすると尿管を摘出し、バイパス手術になる可能性もでてきました。
手術自体も命懸けだと言われました。
ですが、このまま放置では時間の問題とのこと。
早急に手術をし助けてほしい、とお願いしました。
私は、もっともっとジジと一緒に過ごしたいです。
皆様、お力を貸してください。
___________________________________________
6/17
当日の早朝、病院からの電話があり、すぐに病院に向かいました。
・膿が溜まっていいる臓器が破裂し、腹膜炎と同時に菌が全身に回ってしまっている。
・心臓の動きが非常に弱くなってしまっている。
・麻酔に耐えられる確率か非常に低いこと。
・最期をお家で迎えさせてあげた方がいいのではないか
・助かる確率が10%程
Dr.の判断では手術はせず静かに看取る事を勧められました・
ですが何もせずに諦めたら後悔すると思い、覚悟を決めて手術をお願いしました。
4時間半の大手術の末、無事に手術を終えることができました。
右の腎臓の摘出、尿管または子宮様の内臓の摘出(病理検査中)、膣を埋める手術、腹腔内の洗浄をおこなったそうです。
それから数日経ち、少しずつご飯が食べられるようになり、立ち上がれるようになり、本当に少しづつですが回復し、無事退院することができました。
ですが、腎臓の数値もよくなく、腎不全のリスクがあるため今後何年も通院が必要です。
ジジの治療には今後も高額な費用が掛かることがわかっています。
今後もジジの命をつないでいくためにどうか力をお借しください。
▼プロジェクトを立ち上げたきっかけ
先天性の奇形がありペット保険には加入できていません。
大学病院や高度医療センターで手術を受ける際、とても高額になるといわれています。
私の家族の治療費を助けていただくなんて果たしていいのだろうか?と考えましたが、闘病している動物たちのページを拝見し、皆様も私と同じように家族を助けたいという気持ちが同じなんだと知り、チャンスをいただきたいとおもいました。
まだまだ子犬を卒業したばかりの1歳です。
もっともっとジジと色々なものを見て、一緒に過ごしていきたいという気持ちでいっぱいです。
▼プロジェクトの内容
ジジの手術等の治療費のご支援お願いします。
皆様からの支援金に関しましては全額ジジの子宮を取り除くための検査・手術費・入院費に充てさせていただきます。治療費が支援金を上回る場合は、差額分は借入を行い、治療いたします。
治療費が支援金を下回った場合は、支援を求めている闘病中の動物への支援、保護団体への寄付を行います。
▼プロジェクトの展望・ビジョン
医師と相談して早めにジジの手術をと考えています。
プロジェクト成立前に手術が必要となった場合でも借入等行い手術をします。
↑実家にいる保護犬のお姉ちゃん(ルーシー)と一緒に。
↑実家にいる保護猫のゆきちとは親友です。
皆様ご支援よろしくお願いいたします。
随時、経過をご報告させていただきます。
診断書や手術の同意書を病院のほうから頂き次第その都度、掲載していきます。
万が一、治療・手術中になくなってしまった場合は、いただいた資金を同じように動物の治療費を必要としている方に、治療費や手術費を除いた金額の全額をこちらのサイトから支援させていただきます。
リターンは、現在ジジの治療費を工面するのが精一杯のため、感謝の気持ちとジジの経過報告等しか行うことができません。またジジが元気になりましたら、私もほかの動物への支援を行っていくことで、皆様の応援していただいたお礼をしていきたく思います。
現在コロナウイルスが蔓延しておりますが、命に関わることですので手術・治療の遅延や中止はありません。
【プロジェクト終了要項】
●治療・手術対象
ジジ(キャバリア、1歳、男の子)
●治療・手術内容
先天性疾患に伴い、雄として生まれたが子宮様の内臓があり、静脈、大腸等に癒着しているため、二次病院での摘出手術。
●治療・手術完了予定日
2021年8月17日
あなたのシェアでプロジェクトをさらに応援しよう!
プロフィール
岐阜県在住です。現在、先天性奇形の愛犬の治療を行っております。大きな病院での治療を必ず行い、これからも一緒に生活していきたいです。
あなたのシェアでプロジェクトをさらに応援しよう!
リターン
1,000円

ジジがんばれ!
近況報告と感謝のメールをおくります。
- 申込数
- 78
- 在庫数
- 制限なし
- 発送完了予定月
- 2021年9月
3,000円

ジジくん応援コース1
感謝のメールを送ります。
ジジの現況報告をさせていただきます。
- 申込数
- 38
- 在庫数
- 制限なし
- 発送完了予定月
- 2021年9月
1,000円

ジジがんばれ!
近況報告と感謝のメールをおくります。
- 申込数
- 78
- 在庫数
- 制限なし
- 発送完了予定月
- 2021年9月
3,000円

ジジくん応援コース1
感謝のメールを送ります。
ジジの現況報告をさせていただきます。
- 申込数
- 38
- 在庫数
- 制限なし
- 発送完了予定月
- 2021年9月
プロフィール
岐阜県在住です。現在、先天性奇形の愛犬の治療を行っております。大きな病院での治療を必ず行い、これからも一緒に生活していきたいです。